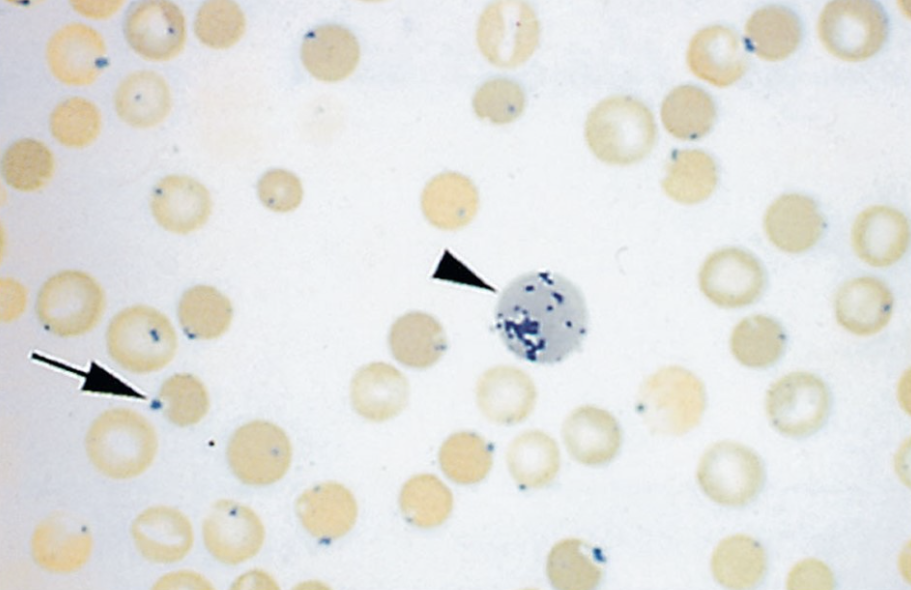

midterm questions and more
1/214
Earn XP
Description and Tags
These will have questions from the midterm, quizzes 3 and 4, and pictures from the PowerPoint review
Name | Mastery | Learn | Test | Matching | Spaced | Call with Kai |
|---|
No analytics yet
Send a link to your students to track their progress
215 Terms
Nonrenal causes of increased levels of BUN might include
the amount of protein ingested

What word best describes the lesion(s) "X" below?
petechiae
A waste product of skeletal muscle metabolism used to assess kidney function is
creatinine
T/F: A coagulation profile (APTT, APT, ACT, PIVKA, etc.) is part of a minimum data base.
false
T/F: A blood clot is also known as a thrombus.
true
A cat was being chased by a dog just before being admitted into your hospital's examination room for a yearly PE and screening labwork. Which of the following changes are you going to most likely see on the CBC?
lymphocytosis, neutrophilia and normal basophils, eosinophils, and monocytes
A hypersegmented neutrophil is most indicative of
an older neutrophil

The arrow is referring to a structure which most likely is
a howell-jolly body
The 2 components of blood are
plasma and formed elements
Which is considered an agranulocyte?
monocyte
If blood is put into a collection tube with an anticoagulant and then centrifuged, the fluid part of the blood will be called
plasma
Which is likely to be seen in a patient with dehydration?
hemoconcentration

the tube labeled “B“ is most consistent with
dehydration

Match the letter in the left column with the specific leukocyte in the right column based on the image below.
A: lymphocyte
B: monocyte
C: eosinophil
D: basophil
E: neutrophil
A decrease in the number of monocytes in circulation is known as
monocytopenia
which cells produce antibodies
plasma cells
The non-cellular, FLUID part of blood that is left over after the blood has been allowed to clot in a container and then centrifuged is called
serum
When carrying a microscope, it is safest to carry it by
the arm and base
When BUN and creatinine are elevated above normal, we call this condition ____________.
azotemia
Which objective lens is most commonly damaged from being exposed to oil?
high-dry objective (40x)
If you find yourself only seeing clearly with one eye while the field of view is blurry for the other eye, which part of the microscope have you failed to adjust?
The diopter ring for the blurry side.
The distance between your eyes when viewing through the ocular lenses is called the
interpupillary distance
The mechanical stage should be _________________________ when ready to store the microscope.
all the way down
Which objective lens should always be used to make your initial lighting and focusing adjustments?
scanning objective
The devices that hold the slide in place on the mechanical stage are known as stage ____________.
clips
Select three anticoagulants commonly found in blood collection tubes.
sodium citrate
lithium or sodium heparin
EDTA
Which pair of cells are most similar to each other in appearance?
acanthocytes and echinocytes
A cellular structure or component that picks up purple stain is considered
basophilic
The "buffy coat" on a centrifuged blood sample within a microhematocrit tube represents
white blood cells and platelets
A dehydrated patient is likely to exhibit ___________________________ .
hemoconcentration

What is this celebrity's last name?
romanowsky
What color are blood collection tubes that contain heparin?
green
Centrifuging a hematocrit tube is done in order to obtain a (an):
PCV and TP
Which structure represents nuclear remnants of a red blood cell?
howell-jolly body

Match the letter in the left column (which correspond to the collection tubes below)with the MOST COMMON USE or ACCURATE DESCRIPTION of the sample (right column) that would be contained or submitted in that tube.
A: urine
B: serum
C: anticoagulated blood for a comprehensive CBC
D: anticoagulated blood for an abbreviated (non-comprehensive) plasma biochemistry
E: coagulation testing/diagnostics

Match the letter in the left column with the best description in the right column.
A: target cell (a type of leptocyte)
B: echinocyte
C: acanthocyte
D: monocyte
E: platelet
F: schistocyte
G: neutrophil

Match the term in the left column with the description in the right column.
A: polychromatophilic cell
B: acanthoycyte
C: echinocyte
D: nucleated erythrocyte

The following blood film was most likely stained using
new methylene blue

The number you will report on the medical record based on the image below is
PCV= 38%
Which values give us information about individual characteristics of red blood cells?
MCHC and MCV
Which of the red blood cell indices indicates cell size?
MCV
If 22,614 leukocytes per microliter were reported and you were told that the differential cell count reported 17% neutrophils per microliter, what would be the absolute number of neutrophils per microliter?
3,844
The packed cell volume is essentially the same measure as the _________________________.
hematocrit (HCT)
Plasma is
The fluid portion of the blood before it has clotted or with an anticoagulant.
______________________ refers to RBCs of different SHAPES.
poikilocytosis
Which pair of red blood cells are most similar to each other in appearance?
hypochromic RBCs and torocytes
Which of the following is most likely to be seen with anemias?
polychromatophilic RBC

The red blood cells below are exhibiting
rouleaux formation

"a" is pointing to
an example of hypochromasia

"b" is pointing to
a polychromatophilic RBC

Which term is LEAST applicable to the population of cells below?
hypochromasia

The arrowHEADS are pointing to
schistocytes

The complete arrows ON THE LEFT image are pointing to
acanthocytes

The arrows are referring to
echinocytes

The shorter arrow is referring to
a spherocyte

The arrow in the center of the image below is pointing to
an eccentrocyte

The arrows below are referring to
stomatocytes
The complete arrow on the left lower part of the image below is referring to
a Heinz body

The arrow is pointing to a
cytoplasmic inclusion

The 3 cells below were found in circulation and all were identified as neutrophils at different stages of maturation. When this is seen, a _________,_________is said to be present
left shift

The red arrow refers to a structure that is
within the normal size range

The cell indicated by the black arrow below has characteristics that represent something
abnormal and inherited

All of the following characteristics of "toxic" changes to neutrophils apply EXCEPT for ___________________.
cytoplasmic eosinophilia
Which of the following leukograms is most consistent with a corticosteroid-induced "stress" leukogram?
monocytosis, neutrophilia, eosinopenia, and lymphopenia

The blood film below could be described as characteristic of a
neutrophilia

The leukocytes found on this image are
characteristic of Pelger-Huet Anomaly.

The basophilic staining structure below the letter "P" is a
macroplatelet

The nucleated basophilic staining cell below is most likely a
a reactive lymphocyte

The cell immediately below the arrow is a _____________ cell.
smudge
The normal Activated Clotting Time (ACT) is
60 to 90 seconds
Which of the following values would be most specific for hepatopathies?
alanine aminotransferase (ALT)
A thrombus is eventually degraded in a process known as
fibrinolysis
Which of the following test results could be done in a clinical setting and would be reported as normal if clotting takes place within 1 to 5 minutes?
buccal mucosa bleeding time
What laboratory test evaluates kidney function and is a breakdown product of protein?
BUN
Which of the following values would be the most specific and sensitive for pancreatitis?
feline pancreatic lipase (fPL)
Which of the following information would NOT be reported in serum biochemistry?
neutrophil count
The coagulation cascade occurs as part of the
chemical phase
An anemia with a decreased MCV would be described as a _____________ anemia.
microcytic
Which collection tube cap color is most likely to be used for most coagulation tests?
blue top
Out of the options below, which enzyme would be best to evaluate if the patient had recent muscle trauma?
creatine phosphokinase
Which analyte would be most specific and sensitive for determining kidney function?
creatinine
Hypernatremia refers to elevated blood
sodium

Which word best describes the lesion "Z" below?
ecchymosis
Match the analyte on the left with the corresponding organ or event on the right.
albumin and globulins:
total protein
Match the analyte on the left with the corresponding organ or event on the right.
ALT, AST, ALP, GGT:
hepatobiliary disease, injury, or lesions
Match the analyte on the left with the corresponding organ or event on the right.
creatinine:
kidney function
Match the analyte on the left with the corresponding organ or event on the right.
electrolyte derangements:
vomiting and diarrhea
Match the analyte on the left with the corresponding organ or event on the right.
albumin and total bilirubin:
liver function
Which of the following coagulation tests requires preheating a grey-top tube?
ACT
The total protein obtained from a microhematocrit tube and a refractometer is composed of:
albumin, liver proteins, and immunoglobulins.
Which of the following collection tubes is most likely to be used when you need to obtain biochemistry analytes?
serum separator tube (sst)
The total protein reported includes the combination of
albumin and globulins
Which of the following values would likely be elevated postprandial?
triglycerides
T/F: The end result of the coagulation cascade is to produce a platelet plug.
false
Vasoconstriction after trauma to tissue vessels occurs as part of the
mechanical phase
The most common inherited coagulopathy in dogs, especially Doberman Pinschers, is
von Willebrand disease
Creatinine concentrations in serum can be influenced by
hydration level
What blood chemistry test is not a test for liver damage?
lipase
Clotting factors like fibrinogen are considered a part of the
plasma
Which of the following tubes can be used to obtain serum biochemistry values?
serum separator tube (sst)